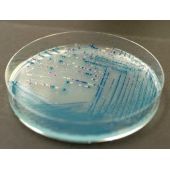
科玛嘉小肠结肠炎耶尔森氏菌显色平板

呼吸道细菌采样套装
呼吸道细菌采样套装 呼吸道细菌的保存检测需要高质量、有效的鼻、咽呼吸道标本,本呼吸道采样保存及转运套装包含咽拭子+细菌采样管+保存液等全套试剂耗材,专门用于收集、保存及运输鼻、咽等呼吸道标本,具有安全、高效、便捷等优点。 产品简介 惠森呼吸道细菌采样套装采用全进口原料进行制备,推
品牌:Hsen货号: H0701S
¥120

大肠埃希氏菌(大肠杆菌)
产品介绍 平台资源号: 菌株保藏编号:SHMCC D83033 中文名称:大肠埃希氏菌(大肠杆菌) 拉丁名称:Escherichiacoli 模式菌株:非模式菌株 其它保藏中心编号:CMCC(B)44102 来源历史:咨询客服 收藏时间: 参考用途:2015版中国药典质控菌株 生物
文献支持品牌:SHMCC货号:SHMCC D83033
¥500

BL21大肠杆菌,Escherichia coli BL21,SHBCC D25054,BL21
菌种名:BL21大肠杆菌 拉丁名:Escherichia coli BL21 菌种编号:SHBCC D25054 其他编号:BL21 模式菌株:非模式菌株 主要用途:科研 具体用途:非毒性蛋白的高水平表达,不能用于由T7启动子驱动的蛋白表达(如pET系列) 生物危害程度:四类 培
品牌:上海保藏生物技术中心SHBCC货号:SHBCC D25054
¥500

Mouse mesenchymal stem cell culture medium 小鼠间充质干细胞培养基
Mouse mesenchymal stem cell culture medium 小鼠间充质干细胞培养基 产品介绍: 小鼠间质干细胞完全培养基特别添加了能有效改善细胞生长状态的营养物质和特别甄选的优质胎牛血清,适合小鼠间质干细胞的体外培养。可维持小鼠间质干细胞良好的增殖速率,
品牌:再康生物货号:ZK-0044126

进口丹麦SSI诊断血清大肠菌,沙门氏菌诊断血清
进口丹麦SSI诊断血清大肠菌,沙门氏菌诊断血清,请咨询客服询价格货期。 用于玻片凝集的大肠杆菌oko池抗血清 Product Reacts with antigen: 测试次数 规格 OK O Pool 1 EPEC/VTEC/STEC O26, O103, O111, O145
品牌:丹麦SSI货号:DM001

OXOIDM17琼脂促销!
OXOIDM17琼脂OXOID经典现货产品,特价促销...... 古朵生物生物为您提供OXOID的新鲜到货产品,且性价比高,供您选择!另外我公司还经营生物试剂、生化试剂,单抗多抗抗体,各种二抗,标记抗体,抗体抗原,蛋白多肽产品等,价格优惠,质量可靠,实时价格和产品详细说明,敬请来
品牌:OXOIDCM货号:0785B
¥1397

ModifiedSclohtens'Broth(MSB)
ModifiedSclohtens’Broth(MSB) 英文名称: Modified Sclohtens' Broth 产品规格: 250g 产品价格: 380元 产品用途: 用于阴沟肠杆菌的培养 用法 称取品本 31.0g,加热溶解于 1000ml 蒸馏水中,分装,121℃高
品牌:沪震生物货号:HZ8720
¥380

Cell cuture bag 细胞培养袋 高效透气 2L/袋,2袋/包
Cell cuture bag 细胞培养袋 高效透气 2L/袋,2袋/包 产品简介 本品由防水透气膜制造,气体可借扩散原理通过微孔膜,液态水或水滴因其表面张力的作用,水分子无法通过。本品材质性能佳,能够很好的扩增悬浮细胞, 安全无毒。 特点: 扩增倍数高:对悬浮细胞具有较好的增殖
品牌:信裕生物货号:XY-3602
¥3602

金黄、色葡萄球菌 CMCC(B) 26003二代定性菌株
38001 金黄色、葡萄球菌 CMCC(B) 26003 1支/盒 第二代定性菌株;可传代。 400.00 38002 枯草芽孢杆菌 CMCC(B) 63501 1支/盒 第二代定性菌株;可传代。 400.00 38003 铜绿假单胞菌 CMCC(B) 10104 1支/盒 第二代
品牌:北京三药货号:CMCC(B) 26003
¥400

Nissui日水微生物培养基-上海仁邦医药
Nissui日水微生物培养基-上海仁邦医药 Nissui日水培养基代理 上海仁邦医药代理销售Nissui日水培养基产品,货期稳定,4周左右,欢迎访问Nissui日水官网或者咨询我们获取更多产品信息。 服务热线:18301939375 日本日水制药株式会社(Nissui)是日本政府
品牌:Nissui日水货号:Nissui
¥10000

胰蛋白胨Oxoid LP0042
胰蛋白胨Oxoid LP0042 蛋白胨是酪蛋白的胰消化。它可用于在任何制定胰腺或胰蛋白酶消化酪蛋白中。酪蛋白是牛奶的主要蛋白质是氨基酸态氮的丰富来源 TRYPTONE Code: LP0042 Tryptone is a pancreatic digest of casein.
品牌:Oxiod货号:lp0042
¥360